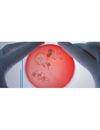

- Home
- Companies
- Bruker Corporation
- Applications
Bruker Corporation applications
IR-Spectroscopy is not limited to gases, solid materials and pure liquids but also facilitates the measurement of solutes in aqueous media. Though, due to the strong and temperature dependent absorption of water, the usage of conventional IR-transmission and ATR accessories is not very suitable for the analysis in water. The CONFOCHECK is a dedicated FT-IR system for the fast, easy and sensitive analysis of aqueous samples. Using this system, preparing, measuring and evaluating any aqueous sample takes typically about 1 minute.
This level is expected to reach over 4 million tons by 2010. Companies that specialize in recycling carpet require a fast, reliable and accurate means of identifying the carpet face fiber type entering recycling streams. Collection of plastics for recycling is increasing rapidly. Plastic recycling faces one huge problem, plastic types must not be mixed for recycling. Even a small amount of the wrong type of plastic can ruin the melt. Whether it is a carpet or plastic, classification and identification of recyclable material can be achieved using Bruker Optics` state of the art spectrometer systems. Bruker Optics has applied the FT-NIR technology and experience to this demanding requirement, and offers the Carpet Analyzer as a dedicated solution for the recycling industry.
Environmental research is perfectly supported with Bruker AXS wavelength dispersive X-ray fluorescence spectrometers (WDXRF) S8 TIGER. Accurate and precise determination of hazardous elements down to the sub-ppm level, reliable identification of elements due to high spectral resolution, high analytical performance even for light elements: The TIGER are perfectly suited for these analytical tasks.
To meet the requirements of new regulations and to protect the environment effectively, industries need techniques that enable the analysis of elements at lowest concentration levels. Bruker X-ray fluorescence (XRF) analysis is the most suitable analytical technique for handling different kinds of materials. Bruker’s XRF, ICP-MS, GC, TOF-MS, FT-IR, CBRNE products and applications help you to monitor contaminated land efficiently and quickly, to determine hazardous elements in the air and water, as well as to classify waste material and to specify products for recycling and disposal. Whether solids, sludge, filters, liquids or powders: there is a fast and simple sample preparation technique for every material type.
Water is essential for life. It is part of the environment, being used in industrial processes and available as tap water. To secure the safety of water that is daily available, the amount of necessary microbiology tests to comply with regulatory requirements are increasing and are heavily relying on quick and accurate answers to confirm the identities of a broad selection of important micro-organisms.
The number of pesticides and other potentially dangerous toxins is increasing constantly, posing special analytical challenges. It is crucial to screen food for the presence of toxins accurately and reliably, and to ensure the safety and quality of nutrition. To do so, we have to have the knowledge about how to deal with several hundreds of different poisonous matters. Bruker delivers solutions that meet the requirements for the identification and quantification of toxicants during the screening of each sample. Bruker’s high-performance TOF-MS is ideally suited for all screening tasks. And Bruker’s SCION series sets a new industry standard for GC-MS. Their easy usability, sensitivisty, robustness and performance make SCION solutions a major technology in food safety.
Hundreds of government agencies and companies have embraced the speed and detection capability of DART® mass spectrometry. The use of open air ionization simplifies analysis of even the most complex samples. Experiment modules can be used to increase the reliability of any method by permitting control of sample positioning. The result: a low cost of operation, easy-to-implement technology that improves your ability to get answers to pressing problems.
Raman spectroscopy has proven to be a technological innovation in the pharmaceutical industry by becoming one of the most popular analytical measurement tools. Coupled with chemometrics methods, it has significant advantages of high sensitivity and resolution in pharmaceutical quantitative analysis. It can be used in the characterization of drug molecules to revealing solid, liquid and solution phase samples arising from polymorphism and quantitative applications in formulations. Stop waiting for the laboratory to catch up to your production line. Tornado provides real-time process analysis for your pharmaceutical manufacturing needs.
MALDI Imaging is a powerful mass spectrometry tool for mapping the distribution of molecules from a thin sample, ranging from small metabolites to large proteins, without molecular tags or labels.
Instruments installed on the line; not in the building next door. Start optimizing your Oil & Gas production in real-time.